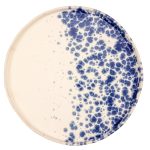
ΠΙΑΤΟ ΕΠΙΠΕΔΟ PHOBOS WHITE BLUE 31 CM LE COQ ΙΤΑΛΙΑΣ

ΜΠΩΛ ΒΑΘΥ PHOBOS WHITE BLUE 18 CM LE COQ ΙΤΑΛΙΑΣ
Η σειρά Phobos White Blue παρουσιάζει το φόβο μέσα από χαοτικές πινελιές σε αποχρώσεις του άσπρου με μπλε. Τη χαρακτηρίζουν τα ζωηρά της χρώματα και οι αντιθέσεις από μπλε πινελιές. Το κάθε κομμάτι είναι μοναδικό, φτιαγμένο στο χέρι, STONEWARE, διακοσμημένο in-glaze. Έχει μεγάλη αντοχή και είναι κατάλληλο για πλυντήρια πιάτων και φούρνους μικροκυμάτων.
| Βάρος | 0.5 κ. |
|---|---|
| Διαστάσεις | 18cm |
| Σχήμα | Στρογγυλό |
| Υλικό | STONEWARE |
| Κατηγορία | Πιάτο Βαθύ |
| Συλλογή | Phobos White Blue Le Coq |
| Χρώμα | ΛΕΥΚΟ, ΜΠΛΕ |
| Χαρακτηριστικά | Πλυντήριο Πιάτων, Φούρνος Μικροκυμάτων |
| Χώρα παραγωγής | EU – ITALY |


Παράδοση παραγγελιών
Εφόσον η παραγγελία έχει δοθεί έως τις 12:00 το μεσημέρι θα παραδίδονται στην κοντινή ζώνη την ίδια ημέρα εφόσον τα προιόντα βρίσκονται σε απόθεμα.
Για τις υπόλοιπες ζώνες περιοχών εντός Αττικής μπορούν να παραδοθούν αυθημερόν η την επόμενη εργάσιμη ημέρα, κατόπιν συνεννόησης με τον πελάτη.
Σε αντίθετες περίπτωσεις, πχ. μη διαθεσιμότητας του προϊόντος, η παράδοση μπορεί να γίνει από 1 έως 5 εργάσιμες μέρες.
Τρόποι αποστολής
- Παραλαβή από το κατάστημα
- Αποστολή με courier
- Αποστολή με μεταφορική
- Αποστολή με Box Now